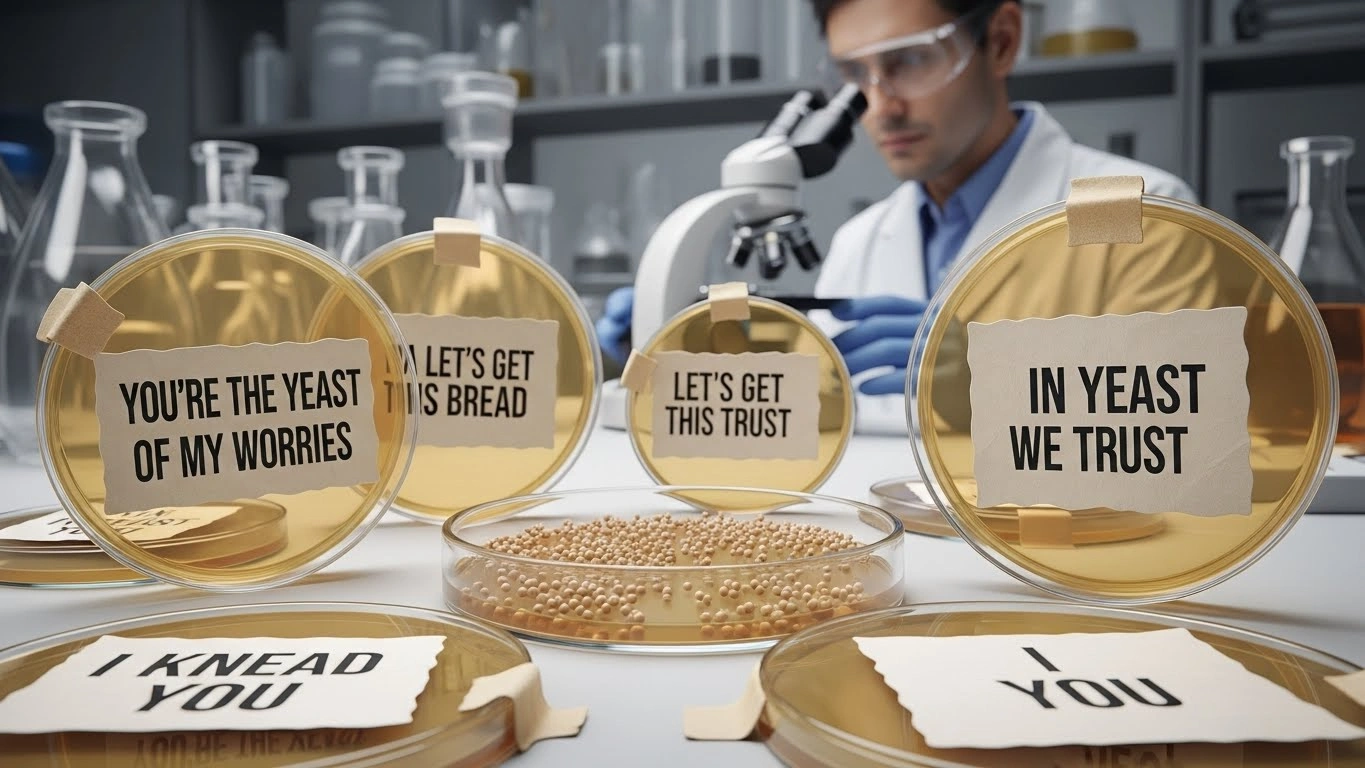
Party & Celebration Yeast Puns

Yeast may be tiny, but its impact is massive—on bread, beer, and now, humor. From baking kitchens to science labs and breweries, yeast puns prove that good jokes, like good dough, need time to rise. These puns are perfect for bakers, brewers, food bloggers, teachers, students, and anyone who appreciates clever wordplay. Carefully crafted to be SEO-friendly, conversational, and easy to scan, this article delivers yeast humor across 15 unique categories, each packed with original puns. Whether you’re proofing dough or proofing your punchlines, these yeast puns are guaranteed to ferment smiles and leave your audience wanting seconds.
🍞 Classic Yeast Puns
I rise to every occasion
Yeast of all my worries
Let’s get this bread growing
Proof that patience pays
I knead yeast in my life
Rise and shine, literally
Yeast makes everything better
Fermenting good vibes only
Doughn’t rush greatness
Yeast going places
I’m on the rise
Proof positive humor
Breadwinner energy
Rising above expectations
Yeast be proud
🥖 Baking & Bread Yeast Puns
Dough happens, yeast helps
Bread is my love language
Yeast brings the loaf together
Baking moods rise slowly
Crust me, yeast matters
Knead patience, add yeast
Loaf at first sight
Bread dreams start with yeast
Let the dough do its thing
Yeast never loafs around
Proofing builds character
Rise before you bake
Soft inside, strong outside
Bread confidence grows overnight
Yeast makes miracles daily
🍺 Brewing & Beer Yeast Puns
Brew can do it
Yeast makes beer believe
Fermentation station activated
Hops and dreams rise together
Ale you need is yeast
Brewing patience pays off
Beer starts small, grows big
Yeast knows how to party
Craft beer confidence
Let it ferment naturally
Brewing takes guts and yeast
Lager than life humor
Sip happens
Yeast fuels the buzz
Brew-tiful results
🧪 Science & Biology Yeast Puns
Microbes with macro impact
Yeast gets cellular attention
Biology that rises
Fermentation is science magic
Living proof of growth
Yeast cells working overtime
Science that bubbles
Growth curves look delicious
Microscopic but mighty
Yeast divides and conquers
Lab humor with culture
Science you can taste
Yeast thrives under pressure
Biology with benefits
Controlled chaos in cells
😄 Funny & Lighthearted Yeast Puns
I’m just here to rise
Yeast me alone
Doughn’t take me lightly
Rising humor only
Proofread my jokes
This pun is fermenting
I knead more sleep
Bread-y or not
Yeast happens
Doughn’t judge me
Let’s roll with it
Rising above awkwardness
Soft jokes hit harder
Crumb on now
Loaf it or leave it
💌 Romantic & Love Yeast Puns
Our love keeps rising
You make my heart proof
Kneaded you always
Love takes time to rise
Fermenting feelings deeply
Bread together forever
You make me feel fluffy
Proofed by patience
Love that grows naturally
Warm hearts rise better
Soft inside, strong bond
Yeast of my worries
Rising romance
Dough-gether always
Love that expands
🎉 Party & Celebration Yeast Puns
Let’s get this dough rising
Celebration starts with bread
Proofing for the party
Rise and celebrate
Yeast makes gatherings better
Bread brings people together
Fermented fun ahead
Toast to growth
Party buns incoming
Rise up the vibes
Dough-lightful moments
Celebrate the rise
Baking joy together
Ferment the fun
Cheers to yeast
🧠 Motivation & Mindset Yeast Puns
Growth takes time
Rise slowly, rise strong
Pressure builds greatness
Trust the process
Proof your potential
Ferment ideas patiently
Growth isn’t instant
Rise with consistency
Yeast teaches patience
Small steps expand
Let yourself develop
Growth happens quietly
Rise naturally
Stay warm, grow strong
Become what you’re proofing
👩🍳 Professional Kitchen Yeast Puns
Kitchens run on yeast
Bakers trust the rise
Proofing is an art
Yeast never clocks out
Bread demands respect
Precision feeds creativity
Dough management matters
Timing is everything
Bakers rise early
Heat reveals talent
Yeast rewards discipline
Kitchens smell like success
Craft built on patience
Consistency tastes better
Bread tells the truth
🌿 Natural & Wild Yeast Puns
Wild yeast, free spirit
Nature knows best
Let fermentation roam
Natural growth hits different
Wild yeast has personality
Nature rises slowly
Ferment without forcing
Organic growth tastes richer
Let nature work
Wild cultures thrive
Yeast follows instincts
Natural timing wins
No rush, just rise
Earth-powered fermentation
Growth without shortcuts
🧁 Desserts & Sweet Yeast Puns
Sweet rolls rise higher
Sugar feeds the fun
Dessert dough dreams
Cinnamon buns of joy
Sweetness needs patience
Yeast loves sugar
Rising treats delight
Dessert proofing time
Soft centers win hearts
Yeast elevates sweets
Sugar and yeast teamwork
Warm treats, warm smiles
Doughnuts with depth
Sweet growth guaranteed
Proofed perfection
🧑🏫 Education & Learning Yeast Puns
Learning takes time to rise
Knowledge ferments slowly
Proof your understanding
Growth through repetition
Yeast teaches biology basics
Learning expands gradually
Concepts need warmth
Small lessons grow
Education bubbles quietly
Let ideas develop
Understanding rises steadily
Patience improves learning
Yeast is a great teacher
Learning needs the right environment
Growth beats speed
🧠 Creativity & Idea Yeast Puns
Let ideas ferment
Creativity needs proofing time
Thoughts rise quietly
Don’t rush inspiration
Yeast fuels imagination
Good ideas expand naturally
Creativity grows under warmth
Let thoughts rest
Proof concepts gently
Innovation bubbles up
Small sparks become loaves
Give ideas time
Rise before release
Creativity loves patience
Ferment brilliance
🧬 Health & Nutrition Yeast Puns
Gut feelings rise naturally
Nutrients need balance
Yeast supports digestion
Health grows steadily
Fermented foods fuel life
Balance feeds growth
Body systems rise together
Nutrition takes patience
Fermentation aids wellness
Small changes matter
Health is a process
Feed yourself wisely
Internal balance matters
Growth starts inside
Nourish consistently
🕰️ Nostalgia & Comfort Yeast Puns
Bread smells like home
Yeast brings childhood back
Comfort rises in ovens
Warm kitchens heal
Familiar flavors comfort
Baking memories last
Old recipes rise again
Yeast connects generations
Comfort takes time
Homemade warmth wins
Traditions ferment slowly
Bread bonds families
Warm loaves, warm hearts
Comfort grows quietly
Home always rises
FAQs
What are yeast puns commonly used for?
Yeast puns are popular in baking, brewing, science education, social media captions, and humor content.
Are yeast puns good for SEO content?
Yes, they improve engagement, dwell time, and make technical topics more approachable.
Can yeast puns be used in education?
Absolutely. They help simplify biology, fermentation, and food science concepts.
Are yeast puns family-friendly?
Yes, all puns here are clean and suitable for all ages.
Do yeast puns work for branding?
Yes, especially for bakeries, breweries, and food brands.
Can yeast puns be used metaphorically?
Yes, they often represent growth, patience, and development.
Are yeast puns suitable for voice search?
Yes, their conversational tone fits voice queries naturally.
How many yeast puns should I use per post?
Two to four per section keeps content humorous but readable.
Why are yeast puns so popular?
Because yeast connects food, science, and everyday life in relatable ways.
Do yeast puns work globally?
Yes, bread and fermentation are universal across cultures.
Conclusion
Yeast reminds us that the best things take time. These yeast puns rise beyond simple jokes—they celebrate patience, growth, creativity, and comfort. Whether you’re baking bread, brewing beer, teaching science, or writing engaging content, yeast humor brings warmth and relatability. Keep these puns proofed and ready, sprinkle them thoughtfully into your content, and remember: when you give ideas time to rise, the results are always worth it.